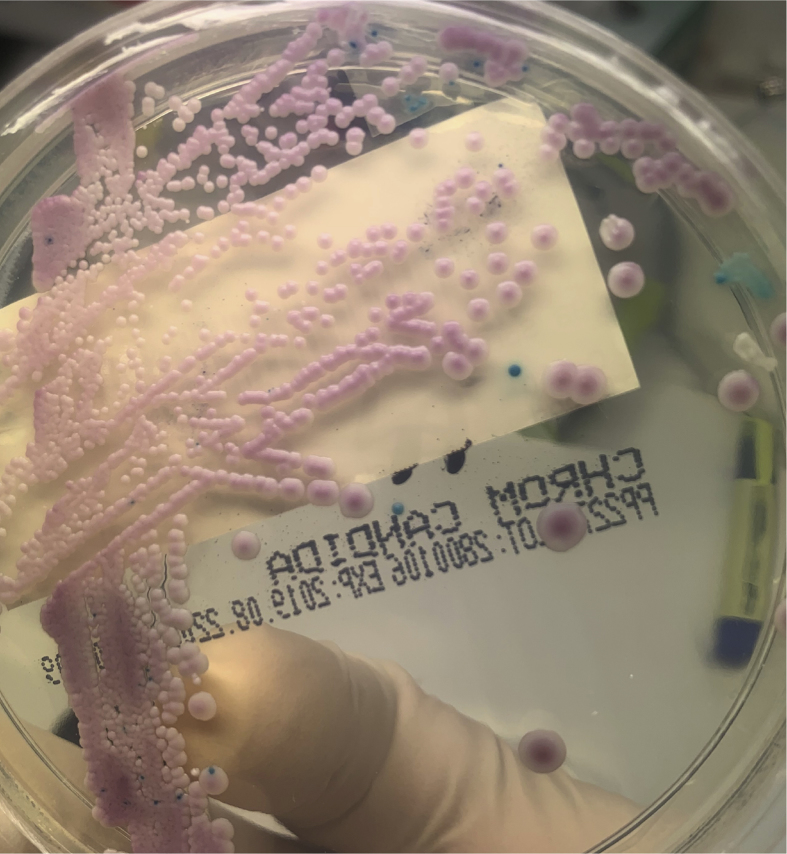
Fig. 1

Abstract
We report the case of a 54-year-old patient with central venous catheter related mixed candidaemia with Lodderomyces elongisporus and Candida parapsilosis, who responded to line removal and anidulafungin therapy.
Mixed candidaemia was detected on Candida chromogenic agar. Identification of the two isolates was confirmed by MALDI-TOF MS (Bruker). Antifungal susceptibility testing revealed different antifungal MICs. This is the first reported case of mixed Lodderomyces candidaemia and outlines laboratory methodology to aid diagnosis and management.
Keywords: Lodderomyces, Candida parapsilosis, Mixed candidaemia
1. Introduction
Lodderomyces elongisporus is an uncommon cause of candidaemia, usually associated with immunosuppression or intravenous access devices [[1], [2], [3], [4], [5], [6]]. It is one of four species recognised within the Candida parapsilosis complex; other species include C. parapsilosis, C. orthopsilosis and C. metapsilosis [[7], [8], [9]]. These four species are physiologically similar and identification by biochemical methods is unreliable, with both Vitek 2 (bioMérieux) and API 20C (bioMérieux) systems generally mis-identifying isolates as C. parapsilosis [1]. L. elongisporus is currently on neither database. On chromogenic Candida agar, L. elongisporus colonies are typically turquoise while other species within the C. parapsilosis complex are pink/lavender [[1], [2], [3],6]. MALDI-TOF mass spectrometry or PCR amplification and DNA sequencing of the internal transcribed spacer region and/or D1/D2 domain of the rRNA gene accurately identify all four species within the C. parapsilosis complex [10].
Mixed candidaemia is uncommon, with rates of 3%–5% [[11], [12], [13]]. Correct identification of mixed infection and speciation of organisms isolated ensures appropriate management. We report the case of a patient with line-associated mixed candidaemia with Lodderomyces elongisporus and Candida parapsilosis, who responded to anidulafungin and line removal.
2. Case
A 54-year-old woman was admitted to hospital with recurrent stoma malfunction and prolapse requiring surgical revision, on a background of prior total colectomy and ileostomy formation for chronic pseudo-obstruction, and short gut syndrome. A long-term Hickman line for total parenteral nutrition (TPN) was last replaced 10 months prior to admission, with a history of previous Hickman line infections secondary to enteric and skin flora.
The patient had a fever on day +1 of admission and a set of blood cultures was collected from the patient's Hickman line. Budding yeasts were identified on microscopy of the anaerobic BacT/ALERT® (bioMérieux) blood culture bottle after 23 hours incubation. Empiric anidulafungin (200mg IV loading dose, followed by 100mg IV daily) was commenced. The subsequent isolate was identified on MALDI-TOF (Bruker) as C. parapsilosis (score = 2.1) after sub-culture. Yeasts were also identified in the aerobic bottle after 28.5 hours incubation. After 2 days incubation of sub-culture of the aerobic bottle, 2 morphologic colony types were noted on chocolate agar, subsequently identified on MALDI-TOF as C. parapsilosis (score 2.26) and L. elongisporus (score 2.04). L. elongisporus colonies were observed to have lighter pigmentation than C. parapsilosis. Sub-culture of the aerobic blood culture bottle revealed pink and turquoise colonies after overnight incubation on Chromogenic Candida Agar (ThermoFisher Scientific) (Fig. 1). MALDI-TOF of the green/blue colonies identified these as L. elongisporus (score 2.15). Antifungal susceptibility testing of both isolates was performed using the Sensititre™ YeastOne™ YO10 plate (ThermoFisher Scientific) (Table 1).
Fig. 1.
Chromogenic Candida Agar (ThermoFisher Scientific) plate with pink (C. parapsilosis complex) and turquoise (L. elongisporus) colonies. (For interpretation of the references to colour in this figure legend, the reader is referred to the Web version of this article.)
Table 1.
Antifungal susceptibility testing results.
| C. parapsilosis MIC (μg/mL) | L. elongisporus MIC (μg/mL) | |
|---|---|---|
| Amphoterecin B | 0.25 | 0.12 |
| Anidulafungin | 0.5 | 0.015 |
| Caspofungin | 0.25 | 0.008 |
| Fluconazole | 0.5 | 0.12 |
| Flucytosine | <0.06 | 0.06 |
| Itraconazole | 0.03 | 0.03 |
| Micafungin | 1 | 0.015 |
| Posaconazole | 0.03 | 0.015 |
| Voriconazole | 0.008 | 0.008 |
C. parapsilosis was also identified in the aerobic bottle of a second blood culture collected on day +2 of admission after 24 hours incubation. The Hickman line was removed on day +6 of admission, and culture of the tip grew >100 colony-forming units of C. parapsilosis (identified by MALDI-TOF) after 24 hours incubation. A PICC was inserted for ongoing TPN.
Anidulafungin was continued for 14 days following Hickman line removal (ceased on day +20). There was no growth in blood cultures collected day +10 and subsequently, and the patient had clinical improvement with resolution of fever following Hickman removal.
3. Discussion
Mixed candidaemia is difficult to identify using non-differential media alone and may have important impact when selecting antifungal therapy. When yeast is observed in positive blood cultures by microscopy, our laboratory routinely sub-cultures onto Chromogenic Candida agar to aid in identification of mixed candidaemia. Although two phenotypes were observed on chocolate agar, identification of mixed yeasts was more readily seen on chromogenic agar.
Antifungal susceptibility patterns of the two isolates were similar but not identical, with low minimum inhibitory concentrations (MICs) to all agents tested. This is consistent with the few published isolates [[1], [2], [3], [4], [5], [6],9]. Although categorically comparable, MICs for anidulafungin and micafungin had more than fourfold difference between our isolates. Local Australian Therapeutic Guidelines [14] and the Infectious Diseases Society of America guidelines [15] recommend empirical echinocandins as first-line therapy for candidaemia. Fluconazole may be used instead in select non-critically ill patients unlikely to have a fluconazole-resistant Candida species. As the patient tolerated anidulafungin and had a clinical response, the decision was made not to alter therapy once antifungal susceptibility results were available.
In addition, consideration of removal of central venous catheters if present must be part of treatment of candidaemia, particularly in non-neutropaenic patients or those in whom a line is considered the source of infection [16]. Our laboratory uses the method described by Maki et al. for processing of central venous catheter tips [17]. L. elongisporus was not identified on tip culture of the Hickman line in our case, which may have been due to the relatively low inoculum of L. elongisporus compared with C. parapsilosis or misidentification as catheter tip specimens are not routinely plated onto chromogenic agar. As the Hickman line was the likely source of candidaemia, removal was an important part of therapy.
Ethical form
This research did not receive and specific grant from funding agencies in the public, commercial, or not-for-profit sectors. The authors have no conflicts of interest to disclose. Consent was obtained from the patient to publish this case report.
Declaration of competing interest
There are none.
Acknowledgements
All contributors met the criteria for authorship.
References
- 1.Lockhart S.R., Messer S.A., Pfaller M.A., Diekema D.J. Lodderomyces elongisporus masquerading as Candida parapsilosisas a cause of bloodstream infections. J. Clin. Microbiol. 2008;46(1):374–376. doi: 10.1128/JCM.01790-07. [DOI] [PMC free article] [PubMed] [Google Scholar]
- 2.Daveson K.L., Woods M.L. Lodderomyces elongisporus endocarditis in an intravenous drug user: a new entity in fungal endocarditis. J. Med. Microbiol. 2012;61:1338–1340. doi: 10.1099/jmm.0.047548-0. [DOI] [PubMed] [Google Scholar]
- 3.Ahmad S., Khan Z.U., Johny M., Ashour N.M., Al-Tourah W.H., Joseph L. Isolation of Lodderomyces elongisporus from the catheter tip of a fungemia patient in the Middle East. Case Rep Med. 2013;2013 doi: 10.1155/2013/560406. 560406. Available at: [DOI] [PMC free article] [PubMed] [Google Scholar]
- 4.Hantanaka S., Nakamura I., Fukushima S., Ohkusu K., Matsumoto T. Catheter-related bloodstream infection due to Lodderomyces elongisporus. Jpn. J. Infect. Dis. 2016;69(6) doi: 10.7883/yoken.JJID.2015.307. [DOI] [PubMed] [Google Scholar]
- 5.Lee H.Y., Kim S.J., Kim D., Jang J., Sung H., Kim M.N. Catheter-related bloodstream infection due to Lodderomyces elongisporus in a patient with lung cancer. Ann Lab Med. 2018;38:182–184. doi: 10.3343/alm.2018.38.2.182. [DOI] [PMC free article] [PubMed] [Google Scholar]
- 6.Al-Obaid K., Ahmad S., Joseph L., Khan Z. Lodderomyces elongisporus: a bloodstream pathogen of greater clinical significance. New Microbe and New Infect. 2018;26:20–24. doi: 10.1016/j.nmni.2018.07.004. [DOI] [PMC free article] [PubMed] [Google Scholar]
- 7.James S.A., Collins M.D., Roberts I.N. The genetic relationship of Lodderomyces elongisporus to other ascomycete yeast species as revealed by small-subunit rRNA gene sequences. Lett. Appl. Microbiol. 1994;19:308–311. doi: 10.1111/j.1472-765x.1994.tb00462.x. [DOI] [PubMed] [Google Scholar]
- 8.Tavanti A., Davidson A.D., Gow N.A.R., Maiden M.C.J., Odds F.C. Candida orthopsilosis and Candida metapsilosis spp. nov. to replace Candida parapsilosis Groups II and III. J. Clin. Microbiol. 2005;43(1):284–292. doi: 10.1128/JCM.43.1.284-292.2005. [DOI] [PMC free article] [PubMed] [Google Scholar]
- 9.Tay S.T., Na S.L., Chong J. Molecular differentiation and antifungal susceptibilities of Candida parapsilosis isolated from patients with bloodstream infections. J. Med. Microbiol. 2009;58:185–191. doi: 10.1099/jmm.0.004242-0. [DOI] [PubMed] [Google Scholar]
- 10.Asadzadeh M., Ahmad S., Hagen F., MEis J.F., Al-Sweih N., Khan Z. Simple, low-cost detection of Candida parapsilosis complex isolates and molecular fingerprinting of Candida orthopsilosis strains in Kuwait by ITS region sequencing and amplified fragment length polymorphism analysis. PloS One. 2015;10(11) doi: 10.1371/journal.pone.0142880. [DOI] [PMC free article] [PubMed] [Google Scholar]
- 11.Jensen J., Munoz P., Guinea J., Rodriguez-Creixems M., Pelaez T., Bouza E. Mixed fungemia: incidence, risk factors, and mortality in a general hospital. Clin. Infect. Dis. 2007;44:e109–e114. doi: 10.1086/518175. [DOI] [PubMed] [Google Scholar]
- 12.Al-Rawahi G.N., Roscoe D.L. Ten-year review of candidemia in a Canadian tertiary care centre: predominance of non-albicans Candida species. Can. J. Infect Dis. Med. Microbiol. 2013;24(3):e65–e68. doi: 10.1155/2013/929717. [DOI] [PMC free article] [PubMed] [Google Scholar]
- 13.Pulimood S., Ganesan L., Alangaden G., Chandrasekar P. Polymicrobial candidemia. Diagn. Microbiol. Infect. Dis. 2002;44:353–357. doi: 10.1016/s0732-8893(02)00460-1. [DOI] [PubMed] [Google Scholar]
- 14.eTG Complete [digital] Therapeutic Guidelines Limited; Melbourne: 2019 Jun. Candida species sepsis (candidaemia) [published 2019 Jun]https://www.tg.org.au [Google Scholar]
- 15.Pappas P.G., Kauffman C.A., Andes D.R., Clancy C.J., Marr K.A., Ostrosky-Zeichner L. Clinical practice guideline for the management of candidiasis: 2016 update by the Infectious Diseases Society of America. Clin. Infect. Dis. 2016;62(4):e1–50. doi: 10.1093/cid/civ933. [DOI] [PMC free article] [PubMed] [Google Scholar]
- 16.Andes D.R., Safdar N., Baddley J.W., Playford G., Reboli A.C., Rex J.H. Impact of treatment strategy on outcomes in patients with candidemia and other forms of invasive candidiasis: a patient-level quantitative review of randomized trials. Clin. Infect. Dis. 2012;54(8):1110–1122. doi: 10.1093/cid/cis021. [DOI] [PubMed] [Google Scholar]
- 17.Maki D.G., Weise C.E., Sarafin H.W. A semiquantitative culture method for identifying intravenous-catheter-related infection. NEJM. 1997;926(23):1305–1309. doi: 10.1056/NEJM197706092962301. [DOI] [PubMed] [Google Scholar]